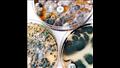
أكل معفن

ماذا يحدث لجسمك إذا تناولت "أكل معفن" دون أن تدري؟
كتب : مصراوي
-
عرض 3 صورة

-
عرض 3 صورة

-
عرض 3 صورة
بالطبع لم يقصد أحد منّا تناول الطعام العفن، لكن قد يحدث دون أن ندري وفجأة نكتشف الأمر، فما العواقب المحتملة، وهل يتفاعل هذا مع الجسم بالسلب؟
نعرض لكم بعض الآثار السلبية للعفن على الطعام في الجسم، كما ذكرت في موقع "brightside".
- يسبب تليف للكبد:
توجد مواد كيميائية سامة يمكن العثور عليها في العفن ويمكن أن تسبب مشاكل صحية خطيرة مثل تلف الكبد والقيء والغثيان والإسهال.
ومع ذلك، يعتمد هذا على بعض العوامل مثل نظام المناعة لديك أو عمرك، يُعرف أحد أكثرها شيوعًا والأكثر سمية باسم الأفلاتوكسين الذي يمكن أن يسبب السرطان.
ولكن لا تنتج كل الأطعمة المتعفنة هذه المادة الكيميائية، ومع ذلك، يمكن العثور عليها في الفول السوداني والذرة.
- ظهور أعراض التسمم الغذائي:
العفن في حد ذاته ليس بهذه الخطورة، كما أن فرص إصابتك بالمرض منخفضة، ومع ذلك، ما يمكن أن يجعلك في خطر هو البكتيريا التي تنمو معها، في هذه الحالة، قد تعاني من أعراض مثل القيء والإسهال والغثيان، وسيعتمد ثقلها على نوع البكتيريا وكمية الطعام الذي تناولته.
- قد يكون لديك حساسية من العفن:
هناك بعض الأشخاص الذين لديهم حساسية من العفن الموجود في الطعام، إذا كنت حساسًا، فمن الأفضل الابتعاد عنه، وفي حالة تناولها عن طريق الخطأ، اتصل بطبيبك على الفور.
الأعراض التي يمكن أن تكون علامة على رد فعل تحسسي هي:
-فرط في دموع العين
-حكة
-طفح جلدي
-صفير في الأذن
-سيلان أو انسداد الأنف
وبحسب ما نشره موقع "Thrillist"، فإن خبراء التغذية أكدوا أن عفن الخبز الشائع ليس ضارًا، ولكن هناك بعض أنواع العفن الخطيرة التي تُنتج مواد سامة تعرف باسم السموم الفطرية، وقد تسبب السرطان، وفقًا لوزارة الزراعة الأمريكية.
هل يمكن قطع الجزء العفن وتناول الباقي؟
يمزق العديد من الأشخاص الأجزاء العفنة ويتناولون باقي الطعام، ولكن هذه الحركة لا تضمن أنك تزيل العدوى الفطرية بالكامل، حيث يمكن أن تصل جذور العفن إلى كل الطعام، لذا يجب التخلص منه كله إذا أصابه العفن جزء منه.
هل تحميص الخبز يقتل العفن؟
تعريض العفن لدرجات حرارة عالية يمكن أن يقتله، ولكن ستظل نكهته موجودة، فمن الأفضل أن تأكل الخبز الطازج.
هل للجبن المتعفن أضرار؟
تحتوي بعض أنواع الجبن مثل الركفورد على عفن، لكنها غير قادرة على إنتاج السموم الفطرية
ولتجنب تعفن الجبن في المنزل يمكن تقليمها بالسكين قبل وضعها في الثلاجة، ويجب التخلص من الجبن الطري المتعفن تمامًا.
كيف يمكنك منع تكون العفن؟
ولتجنب عفن الطعام في الثلاجة يجب تغطية الأطعمة جيدًا في الثلاجة بإحكام سواء بغلاف بلاستيكي أو معدني، وتناول الطعام المحفوظ خلال أربعة أيام، وعدم ترك الطعام القابل للعفن بالخارج أكثر من ساعتين.


















































